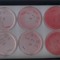
Rich

Comments
Jannisen87
· 3y11/10
Jannisen87
· 3yMasterpiece again!
Jannisen87
· 3yBanger
YÉAHΩIRC
· 6yreally crazy track !
Jannisen87
· 6yYES
Durdu
· 7yamazing! <3
Rhetorikolas
· 8ywow
Rich
· 9yultra geilo !
cloneofotto
· 10ysick track
kaëti
· 10ytrack id plzzz=)